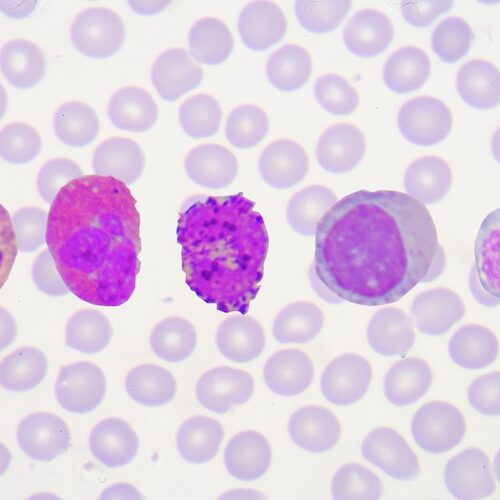

6 simple signs your body is ageing well
Skin – The Emotional Organ
Reflexology for Deep Relaxation and Well-Being
Proactive Longevity: Simple Steps to Stay Healthy for Life
The Vagus Nerve Part 3: – Steps you can take
Practical techniques to help you “tune into calm” and support your vagus nerve — easy habits for a calmer, healthier you.
The Vagus Nerve Part 2: – Why It Deserves Your Attention
Discover how the vagus nerve supports balance, immunity, and healing — and why understanding this “great nerve” matters for overall wellbeing.
The Vagus Nerve Part 1: Massage and the Vagus Nerve – A Surprising Connection
Massage, anatomy, and the vagus nerve: discovering how breathwork and massage activate calm, reduce stress and promote natural healing.
Meet Tom Woolner, our newest Sports & Remedial Therapist
After standout training at OSSM and Cotswold Academy, plus Hydrotherm, pregnancy and oncology massage, Tom joins us Thursdays and Fridays.
Introducing Leia – Massage Therapist and Pilates Teacher at MMC
With roots in ballet and Pilates, Leia brings curiosity, care, and expertise to massage, supporting trust, healing and body awareness.
DIY – The Perils of Painting and Decorating
DIY decorating is a common cause of injury. Here are the top four issues we see—and how they happen.
Case Study: Maddie’s 9-Year Journey Out of Pain – How Massage Matters Changed Everything
After nine years of pain and no answers, Maddie found lasting relief—thanks to a diagnosis no one else had spotted.
Gardening: Joy, Graft, and the Occasional Twinge
Gardening is great for the soul – and tough on the body. Here’s how to look after yours this spring.
Meet the Team: Tomas Woolner
From Town Planning to Trigger Points – An interview with one of our newest massage therapists.
Why Moving Your Body Could Help Protect It from Cancer
From prevention to support during treatment – the growing role of exercise in cancer care.
Arthritis: The Link Between Diet & Inflammation
How Diet, Inflammation, and Lifestyle Choices Impact Arthritis and Effective Ways to Manage Symptoms.
Stay Injury-Free This Spring with Prehab
Prevent injuries with prehab. Strength training, stretching, and massage keep you strong, mobile, and pain-free.
How Old Are You Really? Understanding Biological vs. Chronological Age
Explore the difference between chronological and biological age, and how lifestyle choices impact aging